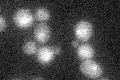
YPR135W
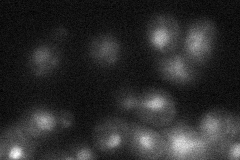
YPR135W
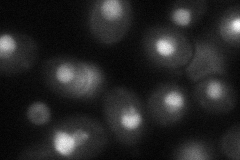
YPR135W
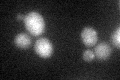
YPR135W
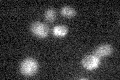
YPR135W

View description
Chromatin-associated protein, required for sister chromatid cohesion; interacts with DNA polymerase alpha (Pol1p) and may link DNA synthesis to sister chromatid cohesion
Localization:
Intensity:
Fold change:
Significance:
-
C’ GFP library in SD
nucleus15.22 -
N' NOP1pr-GFP in SD

nucleus127.079 -
N' TEF2pr-mCherry in SD

nucleus242.617 -
N' NATIVEpr-GFP in SD
nucleus20.9147 -
N' TEF2pr-VC and Cyto-VN in SD
nucleus56.3122 -
C’ GFP library in SD+DTT
nucleus19.761.29No -
C’ GFP library in SD+H2O2

nucleus14.30.93No -
C’ GFP library in Starvation Media
nucleus17.251.13No -
C’ GFP library on the background of Pup2-DaMP

nucleus -
C’ GFP library on the background of CCT mutant

nucleus15.80221.03792No
